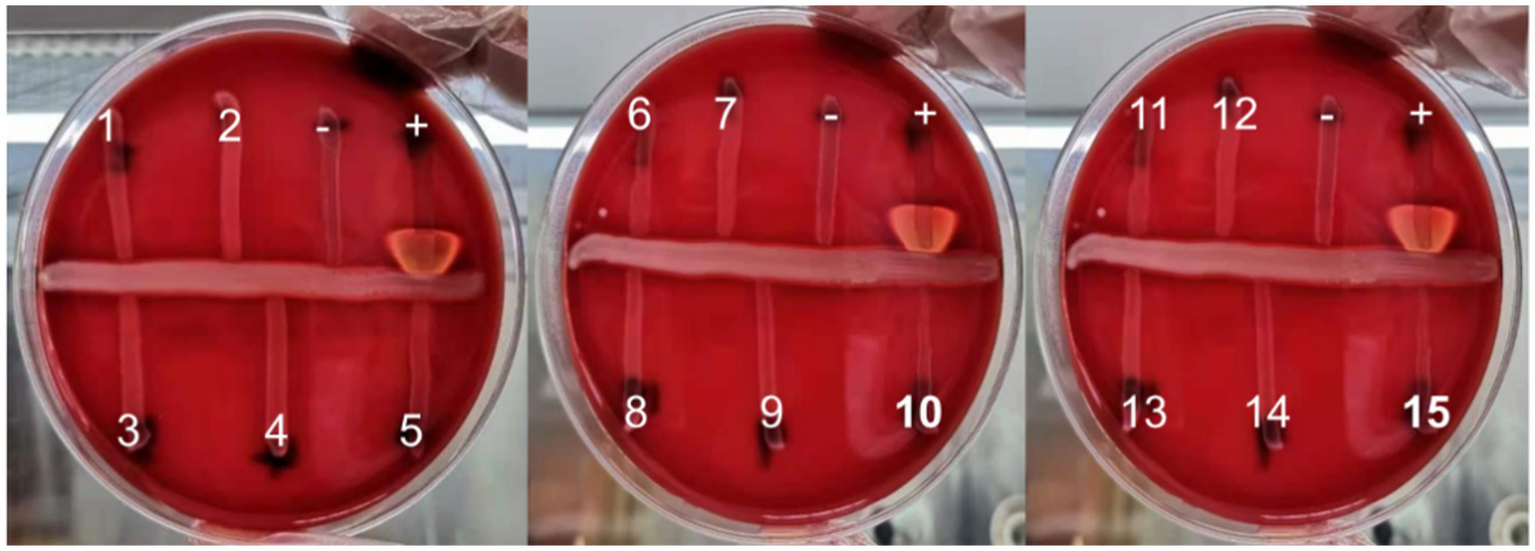
Figure 1

Abstract
Background:
Streptococcus agalactiae can produce CAMP factor, which can promote the β-hemolysin activity of Staphylococcus aureus, forming an arrow-shaped hemolysis enhancement zone at the intersection of the two bacterial species on a blood agar plate. This characteristic feature of Streptococcus agalactiae has led to the widespread use of the CAMP test as an identification method.
Methods:
Vaginal/rectal swabs, collected from women at 35–37 weeks of pregnancy, were first inoculated into a selective enrichment broth media, then subcultured onto GBS chromogenic agar and 5% sheep blood agar sequentially. The VITEK-2 automatic identification system and MALDI-TOF MS were initially employed for identification, followed by the CAMP test. CAMP-negative strains underwent 16S rDNA and cfb gene sequence analysis, as well as bacterial multilocus sequence typing.
Results:
A total of 190 strains were isolated, with 15 identified as CAMP-negative. Further 16S rDNA gene sequence analysis confirmed that all 15 strains were Streptococcus agalactiae. The MLST typing assay revealed that these 15 strains were of the ST862 type. The cfb gene was amplified and electrophoresed, but no specific fragments were found, indicating that these strains lack the CAMP factor due to cfb gene deletion. Antibiotic susceptibility tests demonstrated no resistance to penicillin, ampicillin, vancomycin and linezolid among the GBS strains. However, there are significant differences in resistance rates to tetracycline.
Conclusion:
This study found that 7.9% of GBS strains isolated from the vagina/rectum of pregnant women were CAMP-negative, suggesting that the CAMP test method or primers targeting the cfb gene should not be used as the sole presumptive test for GBS identification.
1. Introduction
Streptococcus agalactiae, also known as group B Streptococcus (GBS), is a Gram-positive coccus commonly found in the gastrointestinal and genitourinary tracts. Research indicates that approximately 11 to 35% of pregnant women are colonized by GBS in the vagina or rectum. (Russell et al., 2017; Bogiel et al., 2021). GBS is the primary pathogen responsible for neonatal infections, with mother-to-child transmission being the predominant mode of infection. Roughly 50% of GBS-colonized pregnant women transmit the bacteria to their newborns. In the absence of intrapartum antibiotic prophylaxis (IAP), 1% ~ 2% of newborns may develop sepsis, meningitis, pneumonia, or other serious complications, potentially leading to neonatal death or neurological sequelae (Puopolo et al., 2019; Geteneh et al., 2020). Since the early 1990s in the United States, GBS screening and IAP have effectively reduced the incidence of neonatal infections caused by GBS (Schrag et al., 2002; Nanduri et al., 2019).
CAMP factor is the primary virulence factor of GBS. The CAMP reaction was initially characterized as the synergistic lysis of sheep red blood cells by Staphylococcus aureus sphingomyelinase and CAMP factor (Christie et al., 1944). For an extended period, the CAMP phenomenon has served as a crucial basis for the laboratory diagnosis of GBS (Jin et al., 2018). Concurrently, the gene encoding CAMP factor, the cfb gene, has been utilized as the target of PCR assays for GBS diagnosis (Carrillo-Avila et al., 2018).
Although the CAMP test is a vital identification method for GBS, instances of GBS with negative CAMP tests have been reported occasionally (Guo et al., 2019). In this study, we employed GBS chromogenic agar plates to screen GBS from perinatal pregnant women, which demonstrated higher sensitivity compared to blood agar plates. We identified 15 strains of CAMP-negative GBS. Our laboratory has conducted preliminary molecular characteristics analyses of these strains, and the findings are presented as follows:
2. Materials and methods
2.1. Strain collection and identification
A total of 1,391 vaginal/rectal swabs were collected from pregnant women at 35–37 weeks of gestation between April 2020 and March 2021 at Pingshan General Hospital of Southern Medical University. To enhance detection rates, the vaginal/rectal swabs were inoculated into a selective enrichment broth media (Jiangmen Kailin Trading Co., Ltd., China) and incubated for 18–24 h at 35–37°C in 5% CO2 conditions. Subsequently, the samples were subcultured onto GBS chromogenic agar plates (Zhengzhou Antu Biological Engineering Co., Ltd., China) for approximately 24 h. The purple colonies were then selected and cultivated on 5% sheep blood agar (Guangzhou Dijing Microbial Science and Technology, China) for another 24 h. Suspected isolates were initially identified using the VITEK-2 automatic identification system (BioMérieux, France) and confirmed by MALDI-TOF MS (BioMérieux, France).
2.2. CAMP test
The CAMP reactions of isolates identified as Streptococcus agalactiae were assessed on 5% sheep blood agar (Guangzhou Dijing Microbial Science and Technology, China) following conventional methods (Guo et al., 2019), Streptococcus agalactiae (ATCC13813) was employed as a positive control, Enterococcus faecalis (ATCC29212) as a negative control, and Staphylococcus aureus (ATCC25923) for the production of β-hemolysin.
2.3. 16S rDNA and cfb gene sequencing
Genomic DNA was isolated and purified using the bacterial genomic extraction kit DP302 (TIANGEN Biotech, Beijing, China). The 16S rDNA gene and cfb gene were amplified using Applied Biosystems 7,500 (Thermo Fisher, Foster City, USA) with primers as reported (Hongoh et al., 2003; Cezarino et al., 2008). Additionally, we designed another set of primers targeting the cfb gene for further verification (Forward: 5′-TGGTAGTCGTGTAGAAGCCTTA-3′; Reverse: 5′-TCCAACAGCATGTGTGATTGC-3′). All amplified fragments were analyzed by agarose gel electrophoresis and sent to Shanghai Personalbio Technology for sequencing. The obtained sequences were blasted in NCBI database. Streptococcus agalactiae (ATCC13813) was used as a positive control in the assay.
2.4. Multilocus sequence typing
Seven housekeeping genes of GBS (adhP, pheS, atr, glnA, sdhA, glcK and tkt) were amplified separately with primers reported (Jones et al., 2003). The amplified products were analyzed by agarose gel electrophoresis and sent to Shanghai Personalbio Technology for sequencing. The obtained sequences were submitted to the MLST analysis website1 to obtain allele numbers and STs.
2.5. Antibiotic susceptibility testing
VITEK-2 susceptibility testing, including penicillin, ampicillin, clindamycin, erythromycin, levofloxacin, tetracycline, linezolid and vancomycin, was conducted following the manufacturer’s instructions using the AST-GP67 card. The results obtained after a maximum of 15 h of incubation were analyzed and interpreted by AES 7.01 software. Staphylococcus aureus (ATCC29213) and Enterococcus faecalis (ATCC29212) were used as quality control strains to ensure the credibility of the results. The D-zone test with erythromycin and clindamycin (OXOID, United Kingdom) placed at 12 mm (edge to edge) distance was performed on 5% sheep blood MH agar (Guangzhou Dijing Microbial Science and Technology, China) and incubated for 20–24 h at 37°C.
2.6. Statistical analysis
The data were reported as numbers (percentages) and compared using the chi-square test. p values <0.05 were considered statistically significant. All data were analyzed using the statistical software SPSS 19.0.
3. Results
3.1. Multilocus sequence typing
A total of 190 Streptococcus agalactiae strains were identified using the VITEK-2 and MALDI-TOF MS systems. Among these, 15 isolates were found to be CAMP-negative strains (Figure 1), representing 7.9% of the total strains. Further confirmation of these strains as Streptococcus agalactiae was achieved through 16S rDNA sequence blast (data uploaded to NCBI GenBank: OQ680135, OQ680134, OQ680136, OQ680133, OQ680132, OQ680130, OQ680128, OQ680127, OQ680129, OQ680125, OQ680126, OQ680014, OQ680017, OQ680013, OQ680016). The 15 strains were then subjected to MLST typing, revealing that all of them belonged to ST862 (adhP = 16, pheS = 1, atr = 4, glnA = 70, sdhA = 9, glcK = 3, tkt = 2). The cfb gene was amplified using two sets of primers, one targeting the upstream region (Figure 2A, Red) and the other targeting the downstream region (Figure 2A, Blue), Agarose gel electrophoresis results indicated chromosomal deletions of the cfb gene in these 15 strains (Figures 2B,C), the sequence of positive control for the cfb gene was uploaded to NCBI GenBank: OQ871565 and OQ693682.
Figure 1
The CAMP test of 15 suspected CAMP-negative isolates of Streptococcus agalactiae (+: positive control, −: negative control).
Figure 2

Agarose gel electrophoresis of the amplified cfb gene from 15 CAMP-negative isolates. (A) Primer design for the cfb gene, with red primers targeting the upstream region and blue primers targeting the downstream region. (B,C) The cfb gene amplified with the two sets primers (lane1 and 17 were positive control; lane2-16 were 15 CAMP-negative isolates; M: DL2000 DNA Marker).
3.2. Antibiotic susceptibility
No GBS resistance to penicillin, ampicillin, vancomycin and linezolid was detected. The resistance rates of the 190 GBS strains to erythromycin, clindamycin, tetracycline and levofloxacin were 62.63, 56.32, 82.11 and 16.84%, respectively. Among these, the resistance rates of CAMP-positive GBS to erythromycin, clindamycin, tetracycline and levofloxacin were 63.43, 56.57, 85.14 and 18.29%, respectively. In contrast, the resistance rates of CAMP-negative GBS were 53.33, 53.33, 46.67 and 0% for erythromycin, clindamycin, tetracycline, and levofloxacin, respectively. No significant difference was observed in resistance rates for erythromycin, clindamycin and levofloxacin; however, a statistically significant difference was found for tetracycline resistance (p < 0.01). The results are presented in Table 1.
Table 1
| Antibiotic | CAMP-positive GBS | CAMP-negative GBS | χ2 | p-value | ||
|---|---|---|---|---|---|---|
| n/Total | Rate (%) | n/Total | Rate (%) | |||
| Penicillin | 0/175 | 0 | 0/15 | 0 | – | – |
| Tetracycline | 149/175 | 85.14 | 7/15 | 46.67 | 13.921 | 0.000 |
| Erythromycin | 111/175 | 63.43 | 8/15 | 53.33 | 0.602 | 0.438 |
| Clindamycin | 99/175 | 56.57 | 8/15 | 53.33 | 0.059 | 0.808 |
| Vancomycin | 0/175 | 0 | 0/15 | 0 | – | – |
| Ampicillin | 0/175 | 0 | 0/15 | 0 | – | – |
| Levofloxacin | 32/175 | 18.29 | 0/15 | 0 | 2.122 | 0.145 |
| Linezolid | 0/175 | 0 | 0/15 | 0 | – | – |
Comparison of antibiotic resistance rates between CAMP-positive and CAMP-negative GBS strains.
n, number of antibiotic resistant strains.
4. Discussion
GBS can cause miscarriage, premature delivery, and premature rupture of membranes through ascending infections in the birth canal of pregnant women. It can also lead to neonatal sepsis and meningitis through vertical transmission between mother and child. Consequently, GBS is a pathogenic bacterium that requires close monitoring during the perinatal period (Simonsen et al., 2014).
Christie et al. first reported in 1944 that the CAMP factor exhibits high specificity for GBS (Christie et al., 1944). In 1979, Bernheimer et al. isolated and purified the CAMP factor (Bernheimer et al., 1979), and its coding gene, cfb, was discovered in 1994 (Podbielski et al., 1994). Subsequent studies revealed that almost all GBS strains contain the cfb gene encoding the CAMP factor. However, some research reports identified CAMP-negative phenotypes (Hassan et al., 2002). The CAMP-negative phenotype in GBS strains with the cfb gene may result from transcription defects, low gene expression, or low CAMP factor activity (Podbielski et al., 1994). Between 2012 and 2018, Tickler et al. collected 31 GBS strains from 12 laboratories in the United States and Ireland, which contained deletions in or near the chromosomal region encoding the hemolysin gene cfb, but only 5 strains lacked the complete cfb gene (Tickler et al., 2019). CAMP-negative GBS has also been identified in China, Guo et al. isolated 4 CAMP-negative strains from 22 GBS strains, but only 1 strain had a cfb gene deficiency (Guo et al., 2019). In this study, we used two sets of primers targeting the upstream and downstream regions of the cfb gene and ultimately identified 15 cfb-deficient GBS strains from 190 isolated GBS strains, with a deficiency rate of 7.9% (15/190). This finding contrasts with the current understanding that the vast majority of GBS (>98%) contain the cfb gene and express the CAMP factor (Jorgensen et al., 2015).
Since most GBS strains contain the cfb gene, many laboratories and companies use the cfb gene as a target for primer design and PCR detection of GBS in vaginal/rectal swabs from pregnant women during the perinatal period (Goudarzi et al., 2015; Tanaka et al., 2016; Ferreira et al., 2018). However, our results indicate that using a GBS detection kit designed for the cfb gene in this region may lead to missed detections. The recently developed Xpert GBS LB XC test targets two unique GBS genes: glucosyl transferase family gene and LysR family gene, exhibiting higher sensitivity and specificity compared to traditional methods (Thwe et al., 2022).
The MLST results of the 15 CAMP-negative strains showed that they all belonged to the ST862 type. This type has been previously reported by Cheng et al. in Guangzhou, South China. However, the six ST862 GBS strains they identified all carried the cfb gene (Cheng et al., 2020), contrasting with our findings. We speculate that this discrepancy may be due to local clonal expansion. The reason for the loss of the cfb gene requires further investigation.
Although the resistance rates of CAMP-negative GBS and CAMP-positive GBS to erythromycin and clindamycin were not statistically significant, the resistance rate of CAMP-negative GBS to tetracycline was much lower than that of CAMP-positive GBS. Whether the absence of the cfb gene affects GBS drug resistance warrants further study.
The CAMP factor is a secreted protein with perforating properties, known to weaken the host’s immune function during systemic infection (Kurosawa et al., 2016). In vivo experiments have demonstrated that the CAMP factor can contribute to, or even cause, animal death, leading to the belief that it is an essential pathogenic factor (Rajagopal, 2009). However, Hensler et al. (2008) conducted in vitro and in vivo experimental studies after allelic replacement of the cfb gene and concluded that the CAMP factor is not necessary for GBS virulence. Therefore, there are still controversies regarding the role and mechanism of the CAMP factor in the infection process. The pathogenicity of these cfb-deficient GBS strains isolated in this study requires further investigation.
5. Conclusion
Based on the results of this study, 7.9% of GBS isolated from the vagina/rectum of pregnant women were CAMP-negative. As a result, the CAMP test should not be solely relied upon as a presumptive method for GBS identification. Utilizing primers targeting the cfb gene could lead to missed detections of GBS, and thus, alternative or multitarget approaches are warranted to ensure optimal diagnostic accuracy.
Funding
This study was supported by grants from the National Natural Science Foundation of China (No. 82272986 to SY), the Natural Science Foundation of Guangdong Province, China (No. 2023A1515010230 to SY), the Science and Technology Foundation of Shenzhen (No. JCYJ20220531094805012 to SY), the Project of Educational Commission of the Guangdong Province of China (No. 2022KTSCX022 to JZ), and the National Key R&D Program of China (No. 2020YFC2006400 to TF).
Publisher’s note
All claims expressed in this article are solely those of the authors and do not necessarily represent those of their affiliated organizations, or those of the publisher, the editors and the reviewers. Any product that may be evaluated in this article, or claim that may be made by its manufacturer, is not guaranteed or endorsed by the publisher.
Statements
Data availability statement
The datasets presented in this study can be found in online repositories. The names of the repository/repositories and accession number(s) can be found below: NCBI - OQ680135, OQ680134, OQ680136, OQ680133, OQ680132, OQ680130, OQ680128, OQ680127, OQ680129, OQ680125, OQ680126, OQ680014, OQ680017, OQ680013 and OQ680016.
Ethics statement
The studies involving human participants were reviewed and approved by the Ethics Committee of Pingshan District People’s Hospital of Shenzhen. The patients/participants provided their written informed consent to participate in this study.
Author contributions
JZ, TF, and SY designed the experiments. JZ, LZ, HL, KX, YZ, and BZ executed the experiments. JZ, LZ, TF, and SY conducted the data analysis. KX and BZ collected/provided the clinical samples and information. JZ and SY wrote the manuscript with input from all of the other authors. All authors contributed to the article and approved the submitted version.
Acknowledgments
We thank Wenrong Kang, Lixian Ye and Juan Zhang for their technical assistance.
Conflict of interest
The authors declare that the research was conducted in the absence of any commercial or financial relationships that could be construed as a potential conflict of interest.
Footnotes
References
1
Bernheimer A. W. Linder R. Avigad L. S. (1979). Nature and mechanism of action of the CAMP protein of group B Streptococci. Infect. Immun.23, 838–844. doi: 10.1128/iai.23.3.838-844.1979
2
Bogiel T. Depka D. Zalas-Wiecek P. Rzepka M. Kruszynska E. Gospodarek-Komkowska E. (2021). Application of the appropriate molecular biology-based method significantly increases the sensitivity of group B Streptococcus detection results. J. Hosp. Infect.112, 21–26. doi: 10.1016/j.jhin.2021.03.008
3
Carrillo-Avila J. A. Gutierrez-Fernandez J. Gonzalez-Espin A. I. Garcia-Trivino E. Gimenez-Lirola L. G. (2018). Comparison of qPCR and culture methods for group B Streptococcus colonization detection in pregnant women: evaluation of a new qPCR assay. BMC Infect. Dis.18:305. doi: 10.1186/s12879-018-3208-4
4
Cezarino B. N. Yamamoto L. Del Negro G. M. Rocha D. Okay T. S. (2008). Diagnosis of neonatal group B Streptococcus sepsis by nested-PCR of residual urine samples. Braz. J. Microbiol.39, 21–24. doi: 10.1590/S1517-83822008000100005
5
Cheng Z. Qu P. Ke P. Yang X. Zhou Q. Lan K. et al . (2020). Antibiotic resistance and molecular epidemiological characteristics of Streptococcus agalactiae isolated from pregnant women in Guangzhou, South China. Can. J. Infect. Dis. Med. Microbiol.2020:1368942. doi: 10.1155/2020/1368942
6
Christie K. Atkins N. Munch-Petersen E. (1944). A note on a lytic phenomenon shown by group B Streptococci. Aust. J. Exp. Biol. Med. Sci.22, 197–200. doi: 10.1038/icb.1944.26
7
Ferreira M. B. de-Paris F. Paiva R. M. Nunes L. S. (2018). Assessment of conventional PCR and real-time PCR compared to the gold standard method for screening Streptococcus agalactiae in pregnant women. Braz. J. Infect. Dis.22, 449–454. doi: 10.1016/j.bjid.2018.09.005
8
Geteneh A. Kassa T. Alemu Y. Alemu D. Kiros M. Andualem H. et al . (2020). Enhanced identification of group B streptococcus in infants with suspected meningitis in Ethiopia. PLoS One15:e0242628. doi: 10.1371/journal.pone.0242628
9
Goudarzi G. Ghafarzadeh M. Shakib P. Anbari K. (2015). Culture and real-time PCR based maternal screening and antibiotic susceptibility for group B Streptococcus: an Iranian experience. Global J. Health Sci.7, 233–239. doi: 10.5539/gjhs.v7n6p233
10
Guo D. Xi Y. Wang S. Wang Z. (2019). Is a positive Christie-Atkinson-Munch-Peterson (CAMP) test sensitive enough for the identification of Streptococcus agalactiae?BMC Infect. Dis.19:7. doi: 10.1186/s12879-018-3561-3
11
Hassan A. A. Akineden O. Lammler C. Huber-Schlenstedt R. (2002). Molecular characterization of phenotypically CAMP-negative Streptococcus agalactiae isolated from bovine mastitis. J. Vet. Med. B Infect. Dis. Vet. Public Health49, 257–259. doi: 10.1046/j.1439-0450.2002.00553.x
12
Hensler M. E. Quach D. Hsieh C. J. Doran K. S. Nizet V. (2008). CAMP factor is not essential for systemic virulence of group B Streptococcus. Microb. Pathog.44, 84–88. doi: 10.1016/j.micpath.2007.08.005
13
Hongoh Y. Ohkuma M. Kudo T. (2003). Molecular analysis of bacterial microbiota in the gut of the termite Reticulitermes speratus (Isoptera; Rhinotermitidae). FEMS Microbiol. Ecol.44, 231–242. doi: 10.1016/S0168-6496(03)00026-6
14
Jin T. Brefo-Mensah E. Fan W. Zeng W. Li Y. Zhang Y. et al . (2018). Crystal structure of the Streptococcus agalactiae CAMP factor provides insights into its membrane-permeabilizing activity. J. Biol. Chem.293, 11867–11877. doi: 10.1074/jbc.RA118.002336
15
Jones N. Bohnsack J. F. Takahashi S. Oliver K. A. Chan M. S. Kunst F. et al . (2003). Multilocus sequence typing system for group B Streptococcus. J. Clin. Microbiol.41, 2530–2536. doi: 10.1128/jcm.41.6.2530-2536.2003
16
Jorgensen JH Pfaller MA Carroll KC (2015) In Manual of clinical microbiology, pp. 383–402. WashingtonASM.
17
Kurosawa M. Oda M. Domon H. Saitoh I. Hayasaki H. Terao Y. (2016). Streptococcus pyogenes CAMP factor attenuates phagocytic activity of RAW 264.7 cells. Microbes Infect.18, 118–127. doi: 10.1016/j.micinf.2015.10.003
18
Nanduri S. A. Petit S. Smelser C. Apostol M. Alden N. B. Harrison L. H. et al . (2019). Epidemiology of invasive early-onset and late-onset group B Streptococcal disease in the United States, 2006 to 2015: multistate laboratory and population-based surveillance. JAMA Pediatr.173, 224–233. doi: 10.1001/jamapediatrics.2018.4826
19
Podbielski A. Blankenstein O. Lutticken R. (1994). Molecular characterization of the cfb gene encoding group B Streptococcal CAMP-factor. Med. Microbiol. Immunol.183, 239–256. doi: 10.1007/BF00198458
20
Puopolo K. M. Lynfield R. Cummings J. J. American Academy of Pediatrics (2019). Committee on fetus and newborn, committee on infectious diseases. Management of Infants at risk for group B Streptococcal disease. Pediatrics144:e20191881. doi: 10.1542/peds.2019-2350
21
Rajagopal L. (2009). Understanding the regulation of group B Streptococcal virulence factors. Future Microbiol.4, 201–221. doi: 10.2217/17460913.4.2.201
22
Russell N. J. Seale A. C. O'Driscoll M. O'Sullivan C. Bianchi-Jassir F. Gonzalez-Guarin J. et al . (2017). Maternal colonization with group B Streptococcus and serotype distribution worldwide: systematic review and Meta-analyses. Clin. Infect. Dis.65, S100–S111. doi: 10.1093/cid/cix658
23
Schrag S. J. Zell E. R. Lynfield R. Roome A. Arnold K. E. Craig A. S. et al . (2002). A population-based comparison of strategies to prevent early-onset group B Streptococcal disease in neonates. N. Engl. J. Med.347, 233–239. doi: 10.1056/NEJMoa020205
24
Simonsen K. A. Anderson-Berry A. L. Delair S. F. Davies H. D. (2014). Early-onset neonatal sepsis. Clin. Microbiol. Rev.27, 21–47. doi: 10.1128/CMR.00031-13
25
Tanaka K. Iwashita M. Matsushima M. Wachi Y. Izawa T. Sakai K. et al . (2016). Intrapartum group B Streptococcus screening using real-time polymerase chain reaction in Japanese population. J. Matern. Fetal Neonatal. Med.29, 130–134. doi: 10.3109/14767058.2014.989496
26
Thwe P. M. Faron M. L. Pride D. T. Cruz A. Gerstbrein D. Nahmod K. A. et al . (2022). Multicenter evaluation of the Cepheid Xpert GBS LB XC test. J. Clin. Microbiol.60:e0135622. doi: 10.1128/jcm.01356-22
27
Tickler I. A. Tenover F. C. Dewell S. Le V. M. Blackman R. N. Goering R. V. et al . (2019). Streptococcus agalactiae strains with chromosomal deletions evade detection with molecular methods. J. Clin. Microbiol.57:e02040-18. doi: 10.1128/JCM.02040-18
Summary
Keywords
CAMP, MLST, Streptococcus agalactiae , CFB, GBS
Citation
Zhou J, Zhang L, Zhang Y, Liu H, Xu K, Zhang B, Feng T and Yang S (2023) Analysis of molecular characteristics of CAMP-negative Streptococcus agalactiae strains. Front. Microbiol. 14:1189093. doi: 10.3389/fmicb.2023.1189093
Received
18 March 2023
Accepted
03 May 2023
Published
24 May 2023
Volume
14 - 2023
Edited by
Svetlana Khaiboullina, University of Nevada, Reno, United States
Reviewed by
Lesley McGee, Centers for Disease Control and Prevention (CDC), United States; Silvia Giono Cerezo, National Polytechnic Institute (IPN), Mexico; Chienchung Lee, Linkou Chang Gung Memorial Hospital, Taiwan
Updates
Copyright
© 2023 Zhou, Zhang, Zhang, Liu, Xu, Zhang, Feng and Yang.
This is an open-access article distributed under the terms of the Creative Commons Attribution License (CC BY). The use, distribution or reproduction in other forums is permitted, provided the original author(s) and the copyright owner(s) are credited and that the original publication in this journal is cited, in accordance with accepted academic practice. No use, distribution or reproduction is permitted which does not comply with these terms.
*Correspondence: Shucai Yang, shucaiyang@link.cuhk.edu.hkTianyuan Feng, psyyfty@sina.com
†These authors have contributed equally to this work
Disclaimer
All claims expressed in this article are solely those of the authors and do not necessarily represent those of their affiliated organizations, or those of the publisher, the editors and the reviewers. Any product that may be evaluated in this article or claim that may be made by its manufacturer is not guaranteed or endorsed by the publisher.